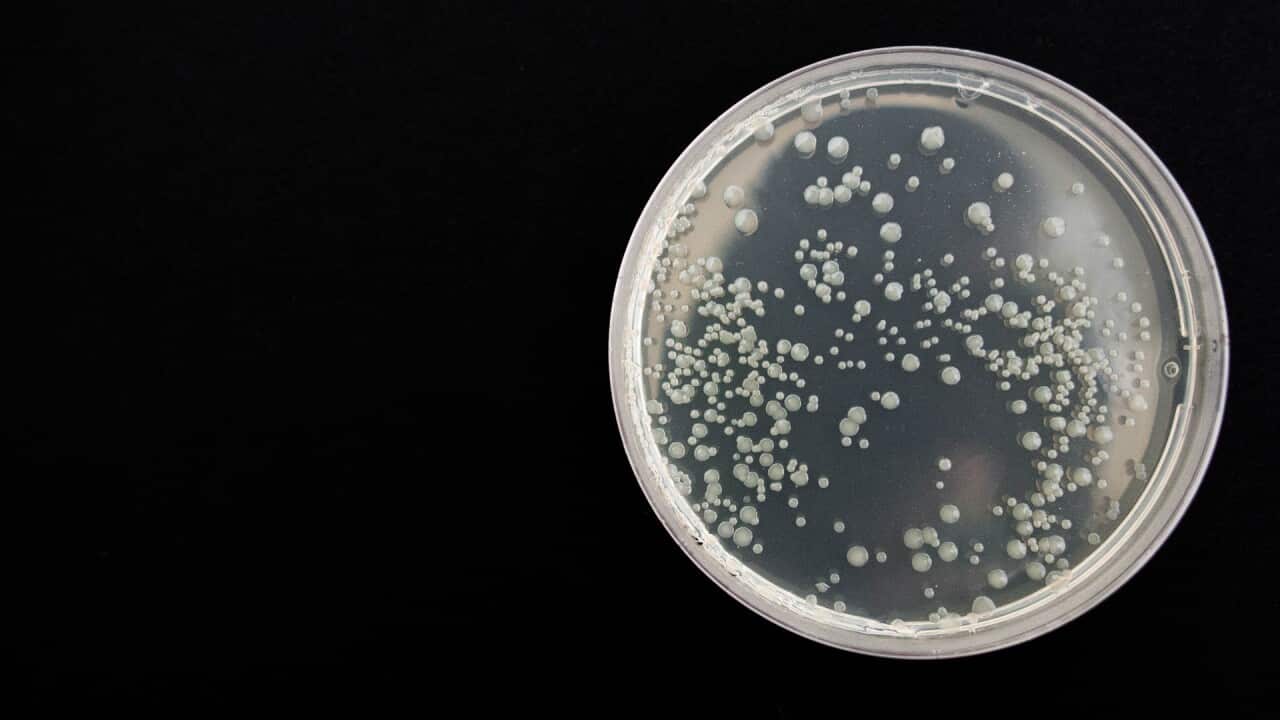
Image for read more article 'READ MORE'

O COVID-19 έχει αναδειχθεί σε μια από τις πιο θανατηφόρες ασθένειες στην Αυστραλία, μετά τις καρδιακές παθήσεις και την άνοια.
Σχεδόν 10.000 Αυστραλοί πέθαναν από τον ιό πέρυσι με τον COVID-19 να συμβάλει σε άλλους 2.782 θανάτους, σύμφωνα με τα στοιχεία της Αυστραλιανής Στατιστικής Υπηρεσίας(ABS) που δημοσιεύθηκαν την Τετάρτη.
Είναι η πρώτη φορά εδώ και περισσότερα από 50 χρόνια, που μια μολυσματική ασθένεια βρίσκεται στις πέντε πρώτες αιτίες θανάτου στην Αυστραλία.
Το 1970, η γρίπη και η πνευμονία ήταν η πέμπτη κύρια αιτία θανάτου, ενώ οι καρδιακές παθήσεις έχουν παραμείνει ως η κύρια αιτία θανάτου από το 1968.
"Αυτή είναι η πρώτη φορά από το 2006 που υπάρχει κάποια αλλαγή στις πέντε πρώτες αιτίες θανάτου", δήλωσε το ABS.
"Το 2006, η άνοια, συμπεριλαμβανομένης της νόσου Αλτσχάιμερ, μπήκε στην πρώτη πεντάδα, ξεπερνώντας τον καρκίνο του εντέρου".
Το ποσοστό θανάτων από COVID-19, αυξήθηκε πέρυσι κατά 23,7 θανάτους ανά 100.000 κατοίκους από το 2021 και 24,5 από το 2020.
Η μέση ηλικία των ατόμων που πέθαναν από τον ιό ήταν τα 85,8 έτη, αντιπροσωπεύοντας το 5,2% του συνόλου των θανάτων.
Οι άνδρες αντιπροσωπέυουν περισσότερους από το 50% των θανάτων λόγω του COVID-19.
Σχεδόν οι μισοί από αυτούς που πέθαναν από τον ιό εμφάνισαν πνευμονία, σύμφωνα με την ABS.
Οι καρδιακές παθήσεις αποτελούσαν το 9,8% των θανάτων για το έτος 2022, ενώ η άνοια -συμπεριλαμβανομένης της νόσου Αλτσχάιμερ- το 9%.
Share